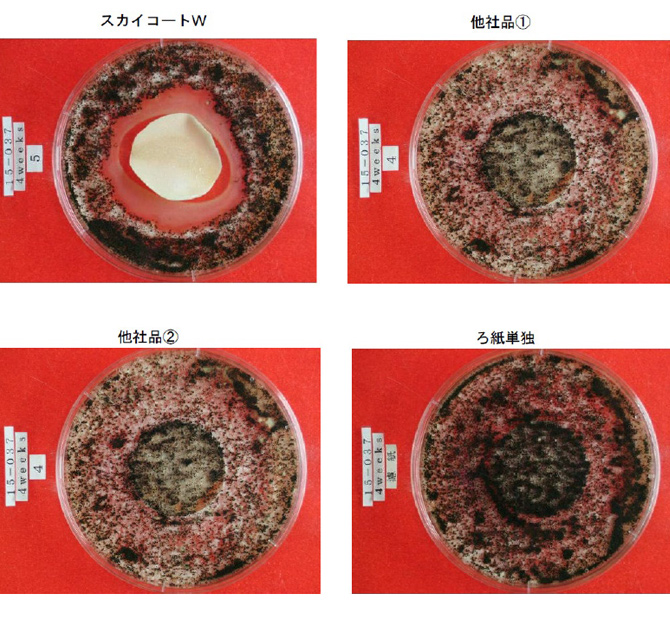

意匠性を担保できるその訳とは?
透明外壁防水材であるスカイコートWは、「透明」であることからも、塗布される壁面のデザイン(意匠性)を担保することも特徴となっております。
そのひとつとして、白化(白濁)しにくい事を試験にて実証しましたが、白化(白濁)は、水分が浸透して起こる現象で防水材の耐水性を問われることでもあり、外壁防水材としての真意を問われるものでも有りますが、防水さえ出来ればよいのか?白化しなければ良いのか?という事もあります。
建物ですので基本的に東西南北の面に壁が存在します。当然ながら北面にはあまり日が当たりません。また周辺近隣の建物の影響で日が当たらない事も多々あります。 そして風の対流なども影響し、日の当たらない北面壁などに、藻(も)やカビが生育してしまうことも多々散見されます。
昨今の風潮で除菌や抗菌が取り沙汰され、それらを機能として取り入れている製品が多数販売されて人気を博しておりますが、防水材にはあまり抗菌という概念はありません。食器等のように日常的に人の手に触れるものでは無いからですが、壁面が藻やカビで侵されていると心的影響はさけられませんし、意匠的にも良くありません。
特にマンションなどではそこに住まいがある事から、自分の住まいの外壁がカビや藻におかされていると思うと、快くありませんし、価値も下がります。商業ビルではなおさらのことでしょう。
透明外壁防水材として、防水だけに留まらず「意匠性の担保」も銘打っているスカイコートWでは、防藻・防カビ性にも注目して開発されています。そこで、除菌剤メーカー様のご協力をあおぎ、防藻・防カビ性について試験をおこないました。
試験材料
●スカイコートWトップ
●他社透明外壁防水材@
●他社透明外壁防水材A
●ろ紙
●菌株
アスペルギルスニゲル
ペニシリウムピノヒルム
クラドスポリウムクラドスポリオイデス
オーレオバシジウムプルランス
トリコデルマビレンス
●藻類
Chlorococcum echinozygotum 緑藻の一種
Chlorella vulgaris 緑色の微細藻類
Oscillatoria neglecta 単藻
Anabaena variabilis 糸状シアノバクテリアの一種
Phormidium ramosum 藍藻
試験内容
JIS Z 2911 かび抵抗性試験方法9.塗料の試験 に基づき同様の処理にて、藻抵抗試験を実施
試験方法
直径30mm の円形ろ紙をスカイコートWトップに浸して引き上げ、均等に付けてから温度
20℃、湿度75%のチャンバー内に吊るして48 時間置き試験片としました。
他社同等製品も同様に処理を実施。
平板培地の培養面の中央に試験片を貼り付け、上記のカビ胞子、藻類の懸濁液1mL を均等
に吹き付けシャーレに蓋をして温度26±2℃に保った場所に置いて7 日間培養を実施。
試験結果
| カビ生育程度 | ||||
|---|---|---|---|---|
| 7 日目 | 14 日目 | 21 日目 | 28 日目 | |
| スカイコートW トップ |
0 | 0 | 0 | 0 |
| 他社品 @ | 2 | 2 | 2 | 2 |
| 他社品 A | 1 | 1 | 1 | 1 |
| ろ紙のみ | 2 | 2 | 2 | 2 |
0:試験片の接した部分に菌糸の発育が認められない。
1:試験片の接した部分に認められる菌糸の発育部分の面積は全面積の1/3を超えない。
2:試験片の接した部分に認められる菌糸の発育部分の面積は全面積の1/3を超える。
防カビ効果4週後の状況
| 藻生育程度 | ||||
|---|---|---|---|---|
| 7 日目 | 14 日目 | 21 日目 | 28 日目 | |
| スカイコートW トップ |
ー | ー | ー | ー |
| 他社品 @ | ± | + | + | + |
| 他社品 A | + | +++ | +++ | +++ |
| ろ紙のみ | +++ | +++ | +++ | +++ |
−:試料面に生育が認められない。
±:試料面の極僅かに生育が認められる。
+:試料面の1/3 以下に生育が認められる。
++:試料面の1/3〜2/3 に生育が認められる。
+++:試料面の2/3 以上に生育が認められる。
防藻効果4週後の状況

写真を見て一目でお判りいただけるように、スカイコートW を浸したろ紙の周辺にはカビや藻の生育は認められておりませんが、ろ紙のみや他社製品については、カビの繁殖や藻の生育が見受けられています。
工業製品における、防カビ性のような機能を有するスカイコートW ということが実証でき、
北面などの日当たりの悪い箇所での使用でも、外観を損ねない(意匠性の担保)優れた透明
外壁防水材であるといえるかとおもいます。
防水だけでは無く、複数の付加価値も有するスカイコートW を、ぜひともご使用下さい。
ぜひ一度、弊社営業部までお問い合わせ下さい。
◆スカイコートWについてはこちらをごらん下さい。
↓ ↓ ↓ ↓ ↓ ↓ ↓ ↓ ↓ ↓ ↓ ↓
https://www.dainichikasei.co.jp/product/skycoat/